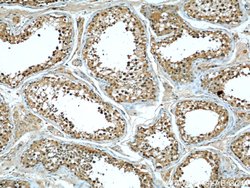
RBAP48 Mouse anti-Human, Clone: 5C4D6, Proteintech 150 &mu;L; Unconjugated:Antibodies,

missing translation for 'onlineSavingsMsg'
Learn More
Learn More
RBAP48 Mouse anti-Human, Clone: 5C4D6, Proteintech
Mouse Monoclonal Antibody
Brand: Proteintech 66060-1-IG-150UL
This item is not returnable.
View return policy
Description
The protein encoded by this gene has sequence similarity with members of the WD40 repeat-containing protein family. The WD40 group is a large family of proteins, which appear to have a regulatory function. It is believed that the WD40 repeats mediate protein-protein interactions and members of the family are involved in signal transduction, RNA processing, gene regulation, vesicular trafficking, cytoskeletal assembly and may play a role in the control of cytotypic differentiation.Specifications
| RBAP48 | |
| Monoclonal | |
| 1.23 mg/mL | |
| PBS with 50% glycerol and 0.02% sodium azide; pH 7.3 | |
| Q09028 | |
| RBBP4 | |
| RBAP48 Fusion Protein Ag6196 | |
| 150 μL | |
| Primary | |
| Human | |
| Antibody | |
| IgG2b |
| Flow Cytometry, Immunohistochemistry (Paraffin), Western Blot | |
| 5C4D6 | |
| Unconjugated | |
| RBBP4 | |
| Histone binding protein RBBP4 | |
| Mouse | |
| Protein A | |
| RUO | |
| 5928 | |
| -20°C | |
| Liquid |
Product Content Correction
Your input is important to us. Please complete this form to provide feedback related to the content on this product.
Product Title
Spot an opportunity for improvement?Share a Content Correction